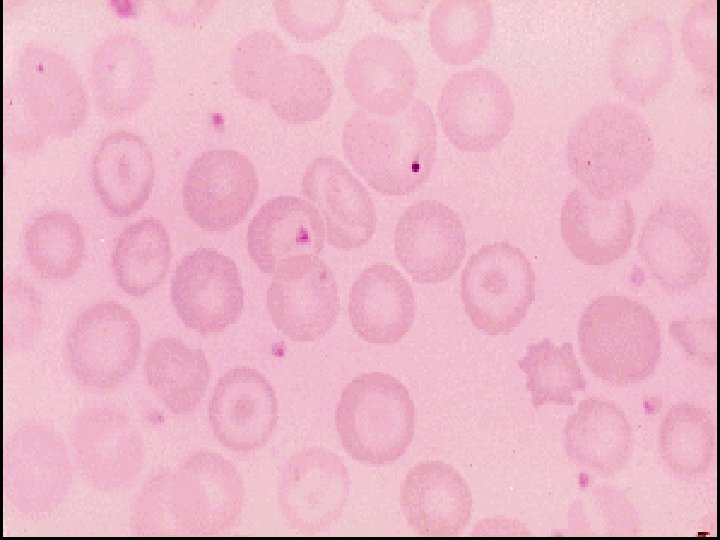

Small intestinal disorders Disorders causing malabsorbtion Celiac disease

Small intestinal disorders

Disorders causing malabsorbtion Celiac disease Autoimmune disorder with a prevalence of § approximately 0. 5 to 1 percent in the United States. (1 in every 100 -200 persons) Inappropriate immune response to the dietary protein § gluten, which is found in rye, wheat, and barley. After absorption in the small intestine these proteins § interact with the antigen-presenting cells in the lamina propria causing an inflammatory reaction that targets the mucosa of the small intestine. Manifestations range from no symptoms to overt § malabsorption with involvement of multiple organ systems and an increased risk of some malignancies


Pathophysiology of coeliac disease

Clinical features In infancy: After weaning: Classical features of diarrhea , malabsorbtion & failure to thrive. In older children: Nonspecific features such as delayed growth. O/E: --Features of malnutrition. --Mild abdominal distension. --Growth & pubertal delay leading to short stature in adulthood.

In adult: Peak onset in third or forth decade. Female 2 > Male. The presentation is variable depending on the severity & extent of bowel involvement: 1 -Florid malabsorbtion. 2 -Nonspecific symptoms. 3 -Folate or iron deficiency anemia. 4 -Oral ulcerations. 5 -Dyspepsia 6 -Bloating.

Diseases associations with coeliac disease: 1 -Type 1 DM. 3 -Thyroid disease. 5 -PBC. 7 -Sjogren Syndrome. 8 -Ig. A deficiency. 10 -Pernicious anaemia. 11 -IBD 13 -Sarcoidosis. 15 -Mysthenia Graves. 17 -Neurological complications: -encephalopathy -cerebellar atrophy -peripheral neuropathy -epilepsy 2 -Dermatitis Herpitiformis. 4 -Downs Syndrome. 6 -Enteropathy associated T cell Lymphoma. 9 -Small Bowel Carcinoma. 12 - Seq. cell carcinoma of the oesophagus. 14 -Ulcerative jejunitis. 16 -Microscopic colitis. 18 -Splenic atrophy

Investigations A-**Jejunal Biopsy**: Characteristic histopathological changes but it is not specific for Coeliac disease. Other causes of villous atrophy are: 1 -Dermatitis Herpitiformis 2 -AIDS Enteropathy 3 -Hypogammaglobulinaemia 4 -Whipples disease. 5 -Tropical Sprue 6 -Lymphoma 7 -Giardiasis 8 -Radiation 9 -Zollinger Ellison Syndrome

Normal small intestine Celiac Disease Normal villi Villous atrophy


B-Antibodies: Ig. A anti-endomyseal antibodies are detectable by immunoflourescence in most untreated cases. They are not quantitative but are sensitive & specific for the diagnosis. Ig. G Abs must be analyzed in patients with coexisting Ig. A deficiency. The tissue transglutaminase Abs ( t. TG ) assay has replaced other blood tests , is semi-quantitative & more accurate in patients with Ig. A deficiency. Abs used for screening for coeliac disease in diarrhea patients & for follow up of patients after treatment.

C-Haematology & Biochemistry: -Full blood count: Microcytic or Macrocytic anaemia Features of Hyposplenism: Target cells , Spherocytes & Howell-Jolly bodies ). -Biochemical tests: Decreased Calcium, Magnesium , total protein , Albumin or Vitamin D.

D-Other investigations: -Barium Follow through. Dilated loops of bowel Coarse or diminished folds Flocculation of contrast -Sugar tests of intestinal permeability are abnormal.

Management 1 -Gluten free diet: Exclusion of WEAT, RYE , BARLEY & OATS. Substituted by: RICE , MAIZE & POTATOS. 2 -Mineral & vitamines supplement: 3 -Steroid : for refractory cases.


Prognosis: 1 -Increased risk of malignancy ( T cell Lymphoma , Small bowel carcinoma & sequamous cell carcinoma of the oesophagus ). 2 -Ulcerative Jejunoilietis. 3 -Metabolic bone disease.


Dermatitis Herpitiformis Characterized by croups of intensely itchy blisters over extensor surface of the limbs & back. Immunoflourecence: granular or linear Ig. A deposition at dermo-epidermal junction.




-Jejunal biopsy: 100% partial villous atrophy even without GI symptoms. -< 10% of Coeliac patients have evidence of DH. Treatment: The rash respond to gluten free diet , but some patients required Dapson ( 100 - 150 mg/d ).

Tropical Sprue Chronic & progressive malabsorption in patients from / in tropics associated with abnormality in small intestine structure & function. Aetiology: Small intestinal bacterial overgrowth with E. Coli , Enterobacter & klebsiella.


Pathology: Partial villous atrophy Subtotal villous atrophy Clinical features: Ø Diarrhea & abdominal distension. Ø Anorexia , fatigue , & weight loss. Ø Acute diarrhea & fever. Ø Chronic condition: features of malabsorption. ØRemission & relapse.

Differential diagnosis: -- Infectious diarrhea & Giardiasis. Management: Tetracycline 250 mg 6 hourly for 28 days + 5 mg folic acid/day.

Small Bowel Bacterial Overgrowth (( Blind loop Syndrome )) >104 /ml of bacteria in duodenum & jejunum due to impairment of normal physiological mechanism controlling bacterial overgrowth in the intestine.

Causes of small bowel bacterial overgrowth Mechanism Hpo or Achlorhydria Impaired intestinal motility Example Pernicious anaemia Partial gastrectomy Long term PPI therapy Scleroderma Diabetic autonomic neuropathy Chronic intestinal pseudo-obstruction Structural abnormalities: Gastric surgery Jejunal diverticulosis Entero-colic fistulae. Extensive small bowel resection. Stricture Impaired immune function Hypogammaglobulinaemia

Clinical features RWatery diarrhea with or with out Steatorrhea. RAnaemia due to B 12 deficiency. RSymptoms of underlying intestinal cause.

Investigations Decrease serum B 12 concentration. Normal or increased serum folate. Barium follow through or small bowel enema: Blind loop or fistulae. Endoscopic duodenal biopsy. Glucose Hydrogen or C 14 - glycocholic acid Breath test.



Management ÆTreatment of underlying cause. ÆTetracycline 250 mg 6 h for 1 week or ÆMetronidazole 400 mg 12 h or ÆCiprofloxacin 250 mg 12 h ÆI. M B 12 may be needed in some cases.

Specific causes of bacterial overgrowth Jejunal Diverticulosis: Usually asymptomatic seen by Barium Follow through. Patients > 50 y when bacterial overgrowth lead to malabsorption. Complications: Perforation, obstruction.

Diabetic Diarrhea Causes: o Autonomic neuropathy: decrease motility & decrease enterocyte secretion. o Coexisting pancreatic insufficiency. o Associated Coeliac disease. Treatment: Antibiotic +Antidiarrheal ( Diphenoxylate 5 mg 8 h or loperamide 2 mg 6 h or opiates, alpha adrenergic agonist Clonidin or Octeriotide may be used.

Progressive Systemic Sclerosis ( scleroderma ) ØCircular & longitudinal small muscle fibrosis. ØMalabsorption due to bacterial overgrowth. ØFeatures of intestinal pseudo obstruction.

Hypogamaglobulinaemia Due to decrease or absent Ig. A & Ig. M in the serum & Jejunal secretion. Clinical presentations: Chronic diarrhea due to bacterial overgrowth& Giardiasis. Diagnosis: Serum IG & intestinal biopsy: decrease or absent plasma cell& nodules of lymphoid tissue , some have histological picture of Coeliac disease. Treatment: regular parantral IG replacement +treatment of Giardiasis.
- Slides: 38